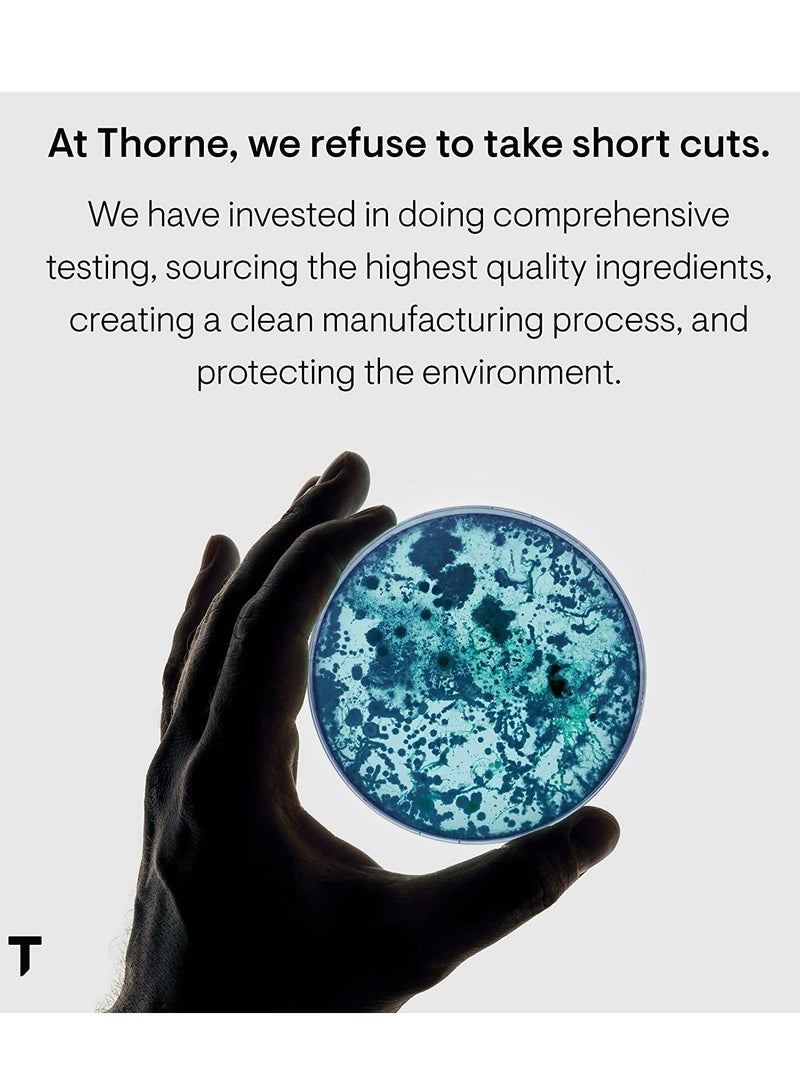
Choleast-900 Red Yeast Rice Dietary Supplement 120 Capsules

18,040,000
مد و پوشاک زنانه
مد و پوشاک مردانه
مد و پوشاک دخترانه
مد و پوشاک پسرانه
ورزشی
خانه و آشپزخانه
ویتامین و مکمل غذایی
کیف، کولهپشتی و چتر
چمدان و ساک مسافرتی
زیبایی و آرایش
عطر و ادکلن
مراقبت پوست
مراقبت مو
مراقبت پوست دست و پا
بهداشت دهان و دندان
لوازم اصلاح سر و بدن
کالای خواب
حوله و لوازم حمام
اسباب بازی
لوازم کودک
بازی کامپیوتری و کنسول
لوازم صوتی حرفهای
تجهیزات صوتی قابل حمل
دوربین فیلمبرداری و عکاسی
دوربین مدار بسته
ساعت هوشمند
غذا و لوازم حیوانات خانگی
لباس
پیراهن شلوار
تاپ، بلوز و کراپ
بارداری
سایز بزرگ
کفش
لباس
تی شرت و پلوشرت
پیراهن
کت و ژاکت
لباس خواب و حوله تن پوش
کلاه
لباس سایز بزرگ
کت و شلوار
کفش
صندل و راحتی
کیف پول، کارت و کلیپس پول
لباس
تیشرت
پلوشرت
کت و ژاکت
کفش
لباس
پیراهن
تیشرت
پلوشرت
کفش
صندل و راحتی
زنانه
مردانه
کودک و نوجوان
تجهیزات ورزشی
فوتبال
بسکتبال
تنیس روی میز
بدمینتون
دوچرخه سواری
موج سواری
ماهیگیری
بوکس و ورزشهای رزمی
کمپینگ
سوارکاری
اسکیت و اسکوتر
بیسبال
کریکت
تجهیزات محافظتی
ورزشی پزشکی
غواصی و اسنورکلینگ
اسپرت فشن و اکسسوری
لوازم فیتنس
لوازم ورزشی فضای باز
لوازم بسکتبال
لوازم فوتبال
لوازم رانینگ
لوازم برقی خانگی
اتو و میز اتو
چرخ خیاطی
لوازم برقی آشپزخانه
تجهیزات پخت و پز
قهوهساز و فومساز شیر
تجهیزات غذا سازی
لوازم تخصصی آشپزخانه و پذیرایی
لوازم سرو و نگهداری نوشیدنیها
ظروف و تجهیزات آشپزخانه
ظروف و لوازم سرو غذا
ظروف و لوازم پخت غذا
دکوراسیون داخلی خانه
خوشبوکننده و دستگاه افشانه عطر
ویتامین و ساپلیمنت
مکملهای ورزشی
مکملهای تقویتی و تنظیمی
کیف و کوله لپ تاپ
کوله پشتی
آرایشی صورت
ابرو و چشم
ناخن
ترمیمی و سرم
مرطوب کننده
لوازم مراقبت پوست
حفاظت در برابر آفتاب
مراقبت دور چشم
شامپو و نرم کننده
لوازم و مواد فرمدهی مو
مراقبت پوست سر
مواد و لازم رنگ مو
مسواک
ست کالای خواب
بالشت و پوزیشنر تخت
پتو
حوله تنپوش
بازیهای فضای باز و تجهیزات پارک
بازیهای آبی و لوازم شنا
ماشینهای سواری، سه چرخه و اسکوتر
ماشینهای دستی، ریموتی و RC
وسایل نقلیه RC و قطعات
فیگور و مجسمه
اسباببازیهای الکترونیکی
اسباببازیهای مدل و حرکتی
اسباببازیهای مشاغل و اماکن
عروسک و لوازم جانبی
عروسک پارچهای و مخملی
یادگیری و آموزشی
کالای خواب
نگهداری و لوازم کودک
تغذیه و نگهداری کودک
بهداشت و مراقبت
لباس و کفش
پخشکننده MP3-MP4
دوربین عکاسی
لوازم جانبی فیلمبرداری و عکاسی
نورپردازی و استودیو
لنز و لوازم جانبی
ساعت هوشمند
ساعت فیتنس ترکر

تحویل بین 29 آذر الی 08 دی
تحویل بین 29 آذر الی 08 دی
 گارانتی اصالت و سلامت فیزیکی کالا
گارانتی اصالت و سلامت فیزیکی کالا
 ارسال رایگان به سراسر کشور
ارسال رایگان به سراسر کشور














![Extra-Strength Omega 3 Fish Oil Supplement - 1000mg per Serving - 600 EPA & 400 DHA and Vitamin E 60 Softgels[1-Month Supply]](https://s3.ir-thr-at1.arvanstorage.com/iap-11/18202259/f72316a7-182d-4dc9-9de0-e000209c2134.jpg)


![Extra-Strength Omega 3 Fish Oil Supplement - 1000mg per Serving - 600 EPA & 400 DHA and Vitamin E 180 Softgels[3-Month Supply]](https://s3.ir-thr-at1.arvanstorage.com/iap-11/18202256/643ec642-3e03-4a7f-aff0-06056e8048a5.jpg)






